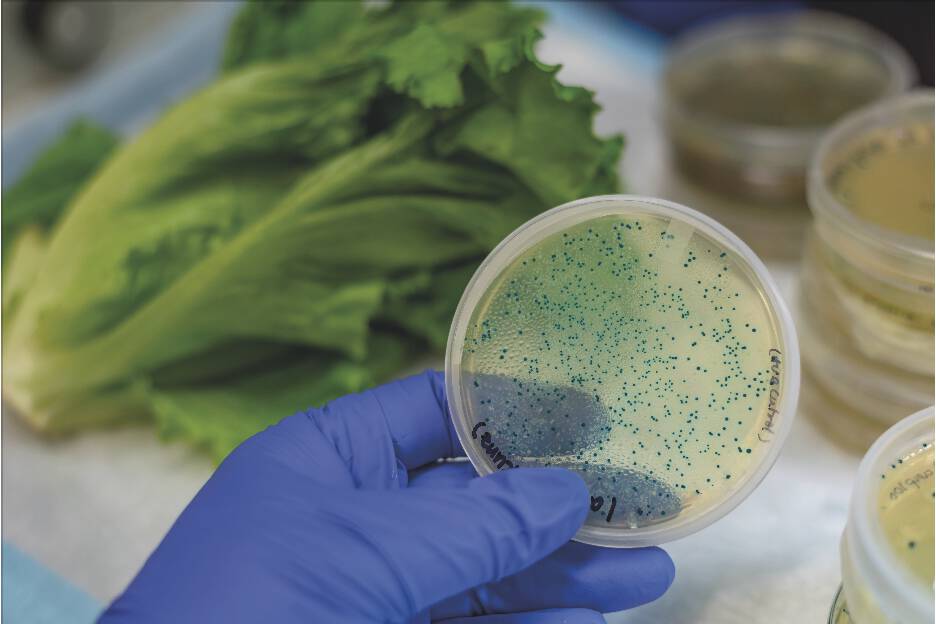
Article image of: Nieuwe norm E. coli in drinkwater

Het tempo van de ontwikkeling van de nieuwe vorm voor versnelde detectie van E. coli in drinkwater is verhoogd. Met moet eerder sneller omdat de resultaten van analyses naar Escherichia coli (E. coli) en bacteriën van de coligroep in drinkwater met kweekmethoden nu vaak minimaal een dag op zich wachten. Het gaat hier om NEN-EN-ISO 9308-1:2014 ‘Water – Telling van Escherichia coli en bacteriën van de coligroep – Deel 1: Methode met membraanfiltratie voor water met een lage achtergrond-concentratie aan bacteriën’.
Het ontwikkelen van een NEN-norm voor een test op basis van reversed transcriptase-PCR (RT-PCR) voor de detectie van E. coli kan dit proces aanzienlijk versnellen. Vaak zijn de resultaten van deze analysemethode al na vier à vijf uur bekend. De levering van betrouwbaar drinkwater aan consumenten kan zo op dezelfde dag weer plaatsvinden. (Bron: NEN)